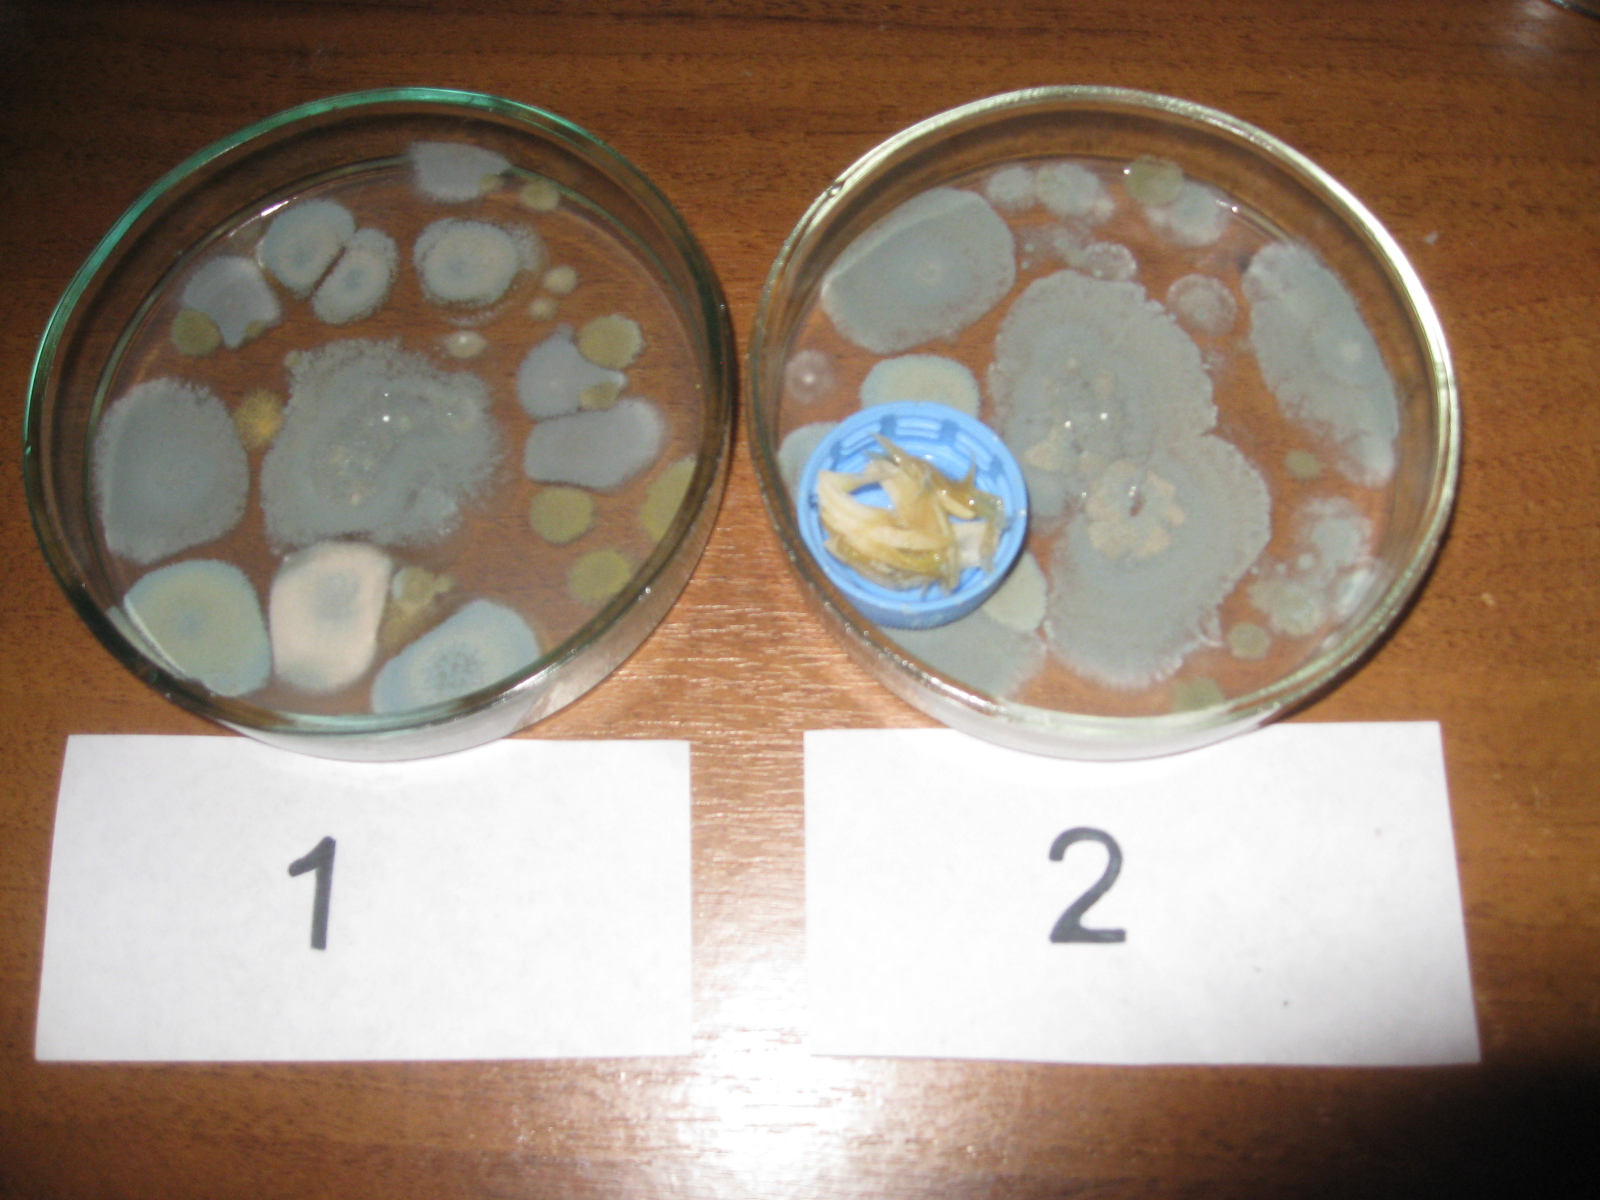
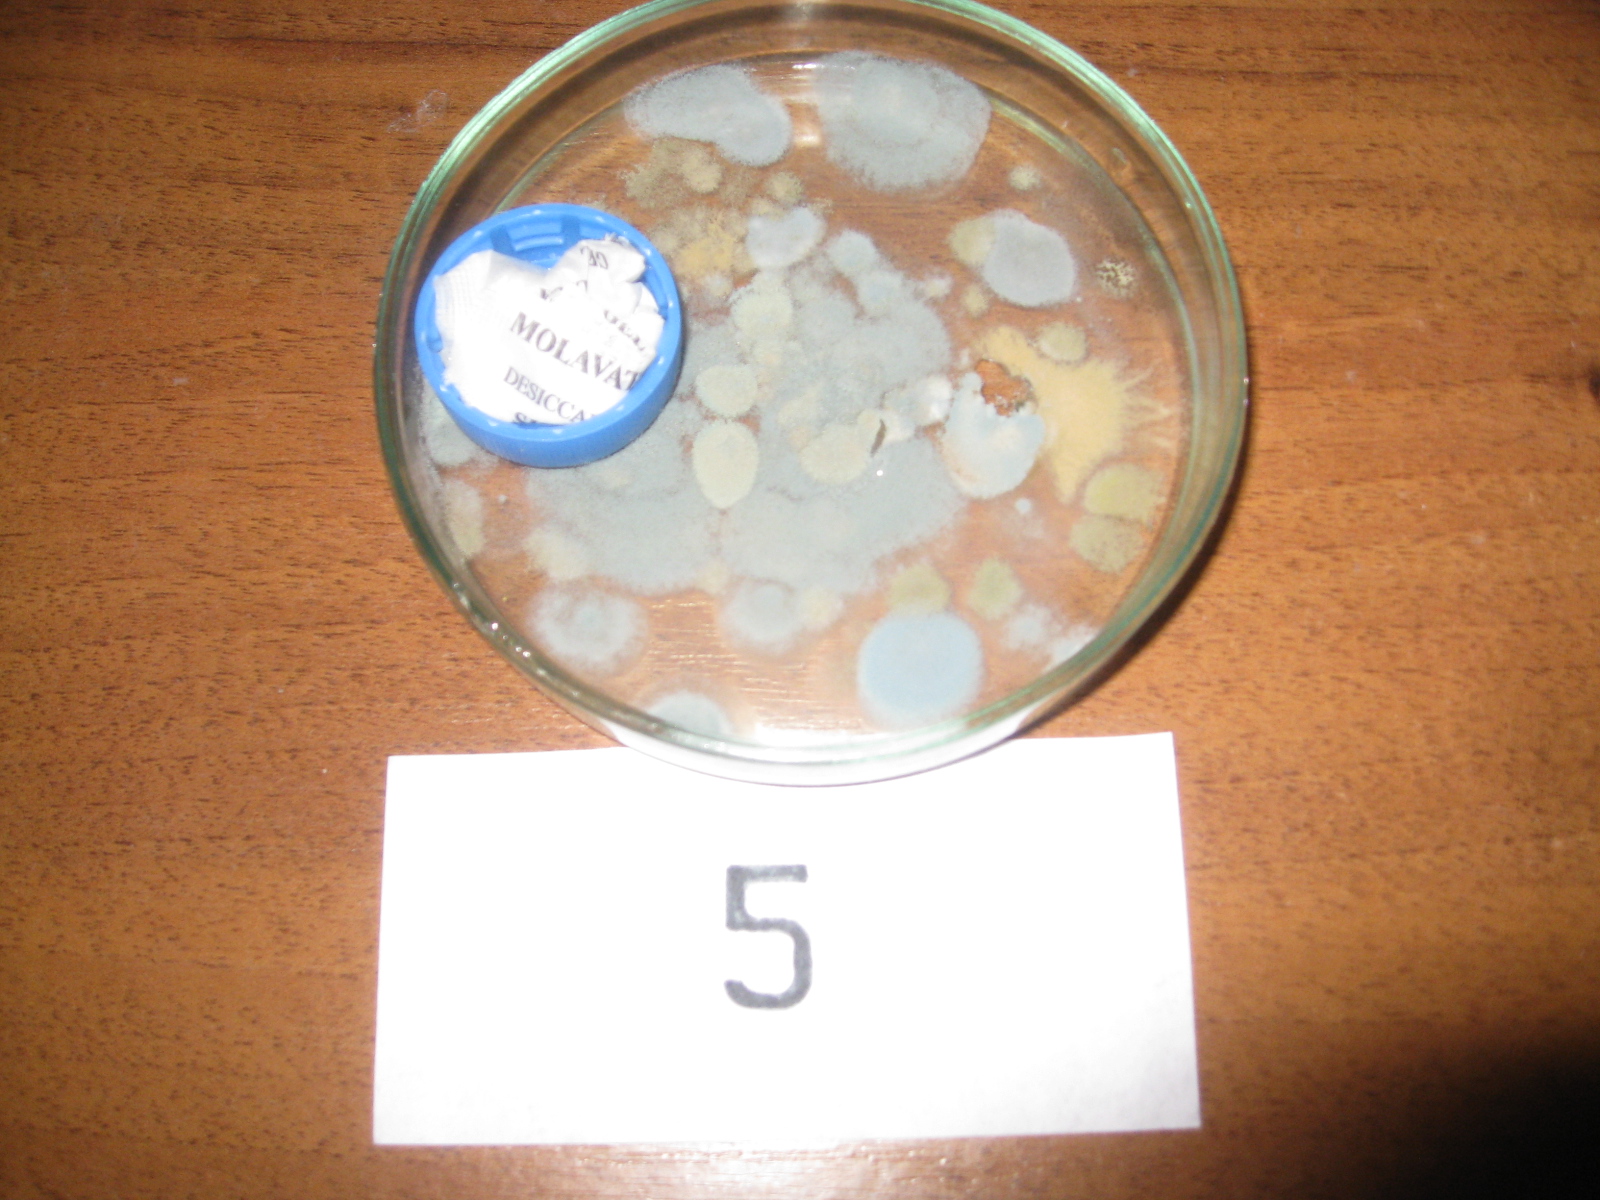

Как быстро вырастить плесень хлебе. Исследовательская работа по биологии "Хлеб и плесень: факторы, влияющие на развитие плесневых грибов".
Прежде чем начинать выращивать плесень на хлебе, давайте разберемся, что она из себя представляет. Это грибы, представители сразу нескольких родов. Самые распространенные: аспергилл, фузариум и пеницилл. При развитии они образуют сильно ветвящийся мицелий без крупных плодовых тел. Именно его мы видим на пропавших продуктах.
Грибы, образующие плесень, делятся на:
Куски можно приготовить до тех пор, пока они не размягчатся в небольшом количестве воды, пара или в скороварке. Метод выпечки очень прост. Чтобы испечь, поместите разрезанные части вниз, в чашку для выпечки немного глубоко и запекайте при температуре 350 градусов в течение 30 минут или более. Посмотрите, приготовлена ли она путем вставки или сверления вилкой. Когда он мягкий, извлеките детали из духовки, дождитесь, пока они не станут холодными, прежде чем использовать их. Если он не очищен, ложка удалит его мягкую мясистость, тогда вы можете использовать пюре для любого рецепта, который вы хотите, или замените в рецептах, где вам нужна консервированная тыква.
- грибки гниения, образуются на древесине (белая и бурая гниль);
- плесневые грибки, растут на бетоне и камнях;
- дрожжевые, развиваются на продуктах питания.
В каких условиях растет плесень
Грибки распространяются по воздуху посредством спор. Попадая на питательную поверхность, они прорастают тоненькими нитями. Для хорошего «урожая» надо соблюдать все условия, которые любит плесень. Если не будет хотя бы одного условия, рост может не только замедлиться, но и прекратиться вовсе.
В микроволновой печи поместите разрезанные стороны на тарелку и варите 15 минут или пока ваша мясистость не станет мягкой. На данный момент, тыква может быть приправлена корицей и коричневым сахаром и служит в качестве сопровождения с едой. Тыкву можно сохранить путем замораживания или розлива. Чтобы заморозить его, готовьте его, как указано выше. Чтобы охладить его, поместите миску с тыквой в холодную воду и периодически помешивайте. Упакуйте в мешки для размещения в морозильнике или в плотно закрытых контейнерах, всегда оставляя ½ дюйма пространства наверху.
- Влажность Вода содержится почти во всех окружающих нас объектах. При разнице температур поверхности и воздуха возможно образование конденсата - в этом месте плесени будет очень уютно. А в продуктах питания вода содержится в достаточном количестве для образования плесени.
- Температура Идеальной для грибка считается температура 20ºС. Именно такие условия поддерживаются в современных квартирах. А вот в холодильнике плесень жить не захочет. И если начнет развиваться, будет делать это очень медленно.
- Проветривание и освещение Отсутствие свежего воздуха и света благоприятно сказывается на развитии грибков, потому что они анаэробы - организмы, получающие энергию без доступа кислорода. И солнечный свет им тоже для этого не нужен.
Процесс выращивания
Таким образом, рассмотрев все необходимые факторы роста, мы можем разработать схему для правильного и быстро выращивания плесени.
Тыква должна быть обработана в скороварке. Вымойте тыквы и удалите семена, нарежьте большими кусками и очистите их. Вырезать сквош в кубики или 1-дюймовые кусочки. Поместите его в миску с кипящей водой, дайте ей кипятить в течение 2 минут. Предостережение: не раздавить или пюре для упаковки. Упакуйте горячие кубики или кусочки в горячие упаковки, оставляя 1 дюйм пространства. Заполните контейнеры кипящей водой с той же жидкостью, не забывая оставить 1 дюйм пространства наверху. Выпустите пузырьки воздуха.
Очистите края контейнера. Отрегулируйте крышки и обработайте их. Процесс в скороварке с 11-фунтовым манометром или в скороварке с весом 10 фунтов и манометром. Пинтас 55 минут и четверти 90 минут. Гладкий вкус тыквы хорошо поддается разнообразным интересным блюдам. Помимо пирога тыквы, его можно использовать в супах, пюре, как блюдо для сопровождения, тыквенный хлеб, деликатесы, кексы и печенье.
Первым делом нужно взять кусок хлеба, желательно белого, потому что он не такой кислый, как черный. Можно его даже намочить, хотя и без воды в нем достаточно влаги.
Чтобы избежать попадания на него кислорода, следует герметично замотать хлеб в пакет. Конечно же, непрозрачный. И положить в теплое место. Можно на батарею, но достаточно будет и просто в угол кухонного шкафа, так как температуры воздуха в квартире достаточно.
От ¼ до ½ чашки сгущенного обезжиренного молока. На сковороде нагрейте оливковое масло на медленном огне. Добавьте лук и медленно соте в течение 6-7 минут. Добавить соевый соус и помидоры на кусочки и повара периодически перемешивать до тех пор, пока томатный сок не испарится, около 5 минут.
Перемешать в суп-чаше. Удалите обжарку с небольшим куриным бульоном, добавьте в миску с супом и добавьте оставшийся куриный бульон и пюре из тыквы. Нагреть и постоянно размешать. В отдельном горшочке варите кусочки картофеля в ½ стакана кипящей воды, пока они не станут мягкими. Когда они будут готовы, используйте ложку с отверстиями для удаления картофеля из воды и передайте их в суп-горшок.
Среднее время от начала эксперимента до первых проявлений плесени - три дня. Чем дольше вы будете его там держать, тем больше станет ваш новый питомец.
Плесень будет расти до тех пор, пока не «доест» тот кусочек хлеба, что вы ей положили. Потом будет интересно рассматривать получившуюся растительность с помощью микроскопа. Скорее всего, вы получите на хлебе не один вид грибка, а сразу несколько.
Добавить брокколи в воду, где картофель готовят и кипятят в течение 4 минут, накрыть крышкой. Добавьте брокколи и воду в суп. Теперь добавьте молоко, необходимое для достижения желаемой консистенции. Приправьте солью и перцем, отведайте ее. Пусть суп готовят на медленном огне, периодически помешивают, пока он не станет горячим, и ароматы смешаны в течение 8-10 минут. Как закуска, сделайте 4 порции.
Завод возник на Ближнем Востоке, культивируется более 500 лет в Сирии и имеет большое значение для вавилонских и египетских народов. Это одна из основных продуктов человечества, занимающая 20% культивируемой площади в мире. На долю Южного региона приходится 90% бразильского национального производства. Средний импорт пшеницы в Бразилии за последние 5 урожая составил 5, 5 млн.
Где хранить хлеб? Эксперимент — видео
Министерство образования и науки Автономной Республики Крым
Малая академия науки школьников Крыма «Искатель»
Тонн по 8 млн. В Баии нет организованных культур для коммерческих производств; Государство может производить пшеницу в Центральном, Южно-Центральном и Западном регионах, зональных для производства пшеницы. Плод, кариопус, сухой, мелкий, называется зерном, развивается через 30 дней после оплодотворения цветка.
Пшеница обеспечивает около 20% калорий из продуктов, потребляемых людьми, имеет белок - глютен - не содержится в других зернах, что делает компонент пшеницы незаменимым для многих продуктов. Пшеница полезна человеку через его непосредственные производные муки и пырей. С мукой готовят различные виды хлеба, лапши, лапши, кепки и равиоли, пшеничное мясо, пшеничный кофе, кексы, пирожные, макароны, блины, пиццу и другие.
Симферопольский городской филиал
Городской конкурс исследовательских работ и проектов
«Исследовательский старт»
Направление: Биология растений
ХЛЕБ И ПЛЕСЕНЬ: ФАКТОРЫ, ВЛИЯЮЩИЕ НА РАЗВИТИЕ ПЛЕСНЕВЫХ ГРИБОВ
Работу выполнила:
Багдасарян Карина Валериковна
учащаяся 5-Г класса
общеобразовательной школы І -ІІІ
Пшеница или цельные пшеничные отруби ежедневно добавляются к кашам, супам, другие обеспечивают хорошее функционирование мужской пищеварительной системы, предотвращающей заболевания толстой и прямой кишки, аппендицит, проблемы с сердцем и другие. Пшеничные отруби используются для говядины, свинины и птицы; Пшеничную солому можно вернуть на землю или использовать в качестве кровати для установки животных.
Прорастание семян появление растения на поверхности: от чрезвычайных ситуаций дает фазу рассады - появление первых 3 истинных листьев. Первый сгусток, растение растет, появляется лист-баннер. В конце вы получите резину. Полное появление ушей, цветение, плодоношение и начало наполнения зерен.
ступеней № 18 Симферопольского
городского совета АРК
Научный руководитель:
Зиновик Елена Валентиновна
кандидат химических наук, учитель
биологии общеобразовательной
школы І-ІІІ ступеней № 18
Симферопольского городского
совета АРК
Симферополь, 2014
ВВЕДЕНИЕ
Люди самонадеянно думают, что мир издавна принадлежит им, разумным и всемогущим. Это не так - плесень (простонародное название грибков) появилась гораздо раньше человека, около 200 миллионов лет назад. Она приспособилась ко всему. Даже если случится катастрофа и мир погибнет, плесень благополучно выживет.
Завершите заполнение зерен, созревание зерна, листьев и шипов. По сути, пшеничные зерна в условиях температуры, света и воды в нескольких регионах. Сорта пшеницы указывают на их климатические требования. В широком смысле потребности. Конец кущения. Мороз и сильные ветры вредны для пшеницы.
Избегайте почв и участков, подверженных заболачиванию. Относительно требовательная культура пшеницы требует для своего питания минеральных элементов азота, фосфата калия, кальция, магния, серы, бора, хлора, меди, железа, марганца, молибдена и цинка. Наиболее необходимыми являются азот и фосфор.
Человечество недостаточно информировано о мире мельчайших существ, к которому принадлежит и плесень - микроскопических грибах. Что мы знаем о них?
Если оглядеться вокруг, то мы все постоянно контактируем с плесенью, только никогда об этом не задумываемся. Мы помним, что вокруг нас постоянно присутствуют бактерии и вирусы, но так же вокруг нас находятся и микроскопические грибы. Плесень есть везде - в поверхностных слоях пресной и морской воды, на поверхности растений, в воздухе, в почвах. Плесневым грибкам комфортно в любых условиях: на живом и мертвом материале. Даже в чистой комнате человек вдыхает воздух, наполненный их спорами.
По результатам и рекомендациям анализа почвы у нас есть указания на использование коррективов почвы и различных удобрений. Известняки наносятся на половину дозы - до вспашки и второй половины до первой уборки. Глубина. Эта операция проводится не менее чем за 60 дней до посадки. Удобрение применяется к почве - улову - непосредственно перед посадкой и должно подвергаться незначительному включению.
Области, исправленные известняком, хорошо оплодотворенные и уже обработанные ранее бобовыми растениями - соевыми бобами, бобами, зелеными навозами, должны быть предпочтительнее. Семена должны быть свободны от вредителей, болезней, энергичных и с высокой прорастанием. Для предотвращения заболеваний - при прорастании и всхожести - перед посевом указывается обработка семян со смесью фунгицидов на основе карбоксина тиурама активного начала для 100 кг семян, чтобы предотвратить появление гельминтоспориоза, угля и других.
Поэтому стоит лишь оставить свежие продукты, консервы, фрукты или хлеб на один-два дня в теплом, сыром помещении, как они тут же подвергаются "нападению" спор, и на предмете разрастается колония плесневых грибков. Хлебобулочные изделия мы привыкли употреблять каждый день, поэтому п роще всего заметить плесень на хлебе. А ведь такой хлеб может стать причиной хронических заболеваний: желудочно-кишечных, сердечно - сосудистых и даже онкологических.
Пшеница должна быть чистой до начала фазы цветения. Обычно достаточно одного-двух сорняков до начала кущения. Избегайте прополки в слоях цветения и цветения. Гербициды можно использовать до конца кущения с продуктами на основе. Почва должна быть хорошо подготовлена и ровной, без комков и соломы на поверхности. Глубина, может удовлетворить. Плотность посева должна обеспечивать наличие 60 установок на линейный метр и 300 растений на квадратный метр.
Следующие формулы используются для расчета количества семян, подлежащих высвобождению в почву. Расчет количества семян для посадки. Количество семян на участок. Он учитывает вес тысяч семян пшеницы - в среднем 42 г. - для рекомендуемых сортов. Посев пшеницы можно производить в бороздах или в ямах.
Нас заинтересовало, какой вид плесени растет на хлебе, что способствует ее развитию. Плесень, как всякие грибы питается органическими веществами, растет на всех продуктах питания, если будут подходящие для нее условия. А какие надо создать условия, чтобы она не появлялась в хлебнице или на других продуктах. Мы решили выяснить этот вопрос
Ручная работа и покрытие семени, сделанного с хвостом или ногами; По сеялкам, согласно требуемой плотности. Посадочные удобрения могут использоваться с хорошим выходом. Сезон посадки в Центральной Бразилии - с января по февраль и с апреля по май. Нерушимая вода, положение источника в отношении орошаемого поля и типа почвы указывают на используемый метод орошения.
Потребность в воде для выращивания пшеницы в течение всего цикла зависит от ее производственного потенциала. В среднем на килограмм наносимой воды производится 8 кг зерен. Предлагаемые методы орошения для малых и средних районов выращивания. С двигателем насоса, трубами и спринклерами или шлангами и спринклерами.
Цель работы : определить факторы, влияющие на развитие плесневых грибов.
Задачи :
Расширить свои знания о плесени через работу с научной литературой;
Выяснить время появления плесени на различных сортах хлеба;
Освоить методику выращивания чистой культуры плесневых грибов;
Определить влияние различных факторов на рост плесневых грибов;
С канавками в контуре, параллельно линиям пшеницы; Оконные трубы ведут воду к бороздам. Орошение урожая пшеницы должно быть начато вскоре после посадки и продлено до 102-го дня после посадки в общей сложности 24 приложения воды на протяжении всего цикла.
Это происходит в сухой пшенице; Вредитель может атаковать от появления до кущения. Гусеница предпочитает стебли пшеницы. Взрослый мотылек коричневый с беловатыми пятнами; Молодая форма - серо-зеленоватая или пурпурная гусеница с коричневой или коричневой головой, которая живет в течение 20 дней. Ущерб, нанесенный, называется «мертвым сердцем».
Определить виды плесени, растущей на хлебе;
Объект исследований: плесневые грибы на хлебе. Предмет исследований : факторы, влияющие на развитие плесневых грибов.
РАЗДЕЛ 1. ОБЗОР ЛИТЕРАТУРНЫХ ДАННЫХ
1.1 Что такое плесень?
Плесенью называют пушистые или бархатистые налеты на растениях и предметах растительного и животного происхождения, которые образуются микроскопическими грибами. Плесень – это грибы, представители совершенно отдельного и огромного царства, которое в сравнении с животными и растениями еще очень плохо изучено. Грибница (мицелий) обычно скрывается под землей, а над землей находится орган размножения, содержащий миллионы спор (как раз то, что в обиходе принято называть грибами – плесень) (см. Приложение, рис. 1). Грибы сочетают в себе признаки растений и животных. Они дышат, как растения, всасывая питательные вещества всей своей поверхностью, но при этом не могут поглощать солнечную энергию и углекислоту. Зато, подобно животным, потребляют органические вещества в готовом виде да ещё умеют размножаться половым путём. Хотя чаще плесени размножаются бесполым и вегетативным способом (спорами и фрагментами гиф мицелия) .
Атака проводится ночью, обычно, и в течение дней гусеницы прячутся под сухими листьями, в комках. Пшеничная гусеница: живая в течение 25 дней, имеет цвет, который варьируется от коричневого до коричневого с белыми и желтыми полосами по бокам. Взрослые - бабочки с бледно-желтым до коричневато-серого цвета, которые живут 8 дней.
Контроль гусениц листового отпарника. Опрыскивание инсектицидами. Он атакует пшеницу с этапа кущения до стадии заполнения зерна; Помимо того, что растение сосать сок из листьев побегов, может передать болезнь карликовым желтым карликовым ячменем. Насекомое маленькое, зеленое, 2-3 мм. Долго известна как растительные вши. Атака вызывает симптомы черных пятен на месте жало, а затем пожелтение листьев.
Плесень распространяется по воздуху в виде микроскопических спор. Попадая в подходящую среду, спора, при необходимой температуре и уровне влажности, начинает прорастать. Она образует подобные нитям клетки, называемые гифами. Когда гифы переплетаются между собой, образуется пушистый клубок нитей - мицелий. Это и есть то, что мы называем плесенью. Внешне плесень также может напоминать грязь или пятна, например, когда она образуется на стенах в ванной комнате между плитками
Симптомы атаки широко распространены пожелтение растений и снижение роста. Корневую тлю можно контролировать с помощью продуктов системного действия и гранул в почву. Уровень для контроля зеленой тли, когда заражение достигает 10% растений или более 10 тлей на шип. Пятнистость.
Это влияет на любой этап цикла пшеницы, устанавливая себя в листьях, стебле, ушах, зернах и корневой системе. На листьях появляются удлиненные темно-коричневые пятна, расширяются и объединяются, чтобы взять весь лист. В стебле и спайке темно-коричневые поражения и в темном пятне зерна вблизи эмбриона и в пятнах корней и гнили являются симптомами.
кафеля (см. Приложение, рис. 2).
Плесень размножается невероятно быстро. В обыкновенной хлебной плесени можно различить маленькие черные точки - спорангии, в которых образуются споры. В одном спорангии содержится до 50 000 спор, каждая из которых способна воспроизвести сотни миллионов новых спор всего за несколько дней! А если условия благоприятные, плесень быстро появится на
книге, обуви или на упавшем дереве в лесу.
На сегодня описано 100 тысяч видов грибов (а по оценкам, на Земле их существует более 1,5 миллиона видов). Около двух третьих из известных видов относятся к плесневым микроскопическим грибам.
Плесневые грибы обладают высоким потенциалом выживания в различных, нередко экстремальных условиях существования: в присутствии малых количеств органических веществ и влаги, при воздействии ионизирующего радиоактивного и ультрафиолетового излучения. Они обитают повсеместно в почве, воде, присутствуют в воздухе, сохраняют жизнеспособность в условиях вечной мерзлоты .
1.2 Плесень – и друг и враг
1.2.1. Берегись – плесень. Когда плесень становится врагом? Об опасных свойствах некоторых видов плесени известно уже давно. В VI веке до н. э. ассирийцы использовали древний вид биологического оружия - спорынью, с помощью которой они отравляли воду в колодцах своих врагов. В средние века отравление той же самой плесенью, которая иногда появляется на колосьях ржи, вызывало у многих людей зуд, судороги, галлюцинации и гангрену. Эта болезнь, известная как эрготизм, называлась тогда «огонь святого Антония», так как многие, кто от нее страдал, совершали паломничество к гробнице святого Антония во Франции, надеясь на чудесное исцеление. Самое сильное канцерогенное (вызывающее рак) вещество, которое выделяет плесень,- афлатоксин. В одной азиатской стране каждый год от действия этого канцерогена погибает 20 000 человек. Это опасное для жизни вещество использовалось в производстве современного биологического оружия . Большинству людей приходится в жизни сталкиваться в основном с двумя видами плесени: черной и зеленой. Опасна ли эта плесень? Всем известно, что нельзя употреблять в пищу несъедобные грибы. Но пищевые отравления могут вызвать и заплесневелые продукты, так как отдельные виды плесени образуют токсичные вещества. Люди могут заразиться и при употреблении в пищу зараженных молочных и других продуктов, на которых есть плесень, могут вдохнуть пыль, содержащую споры этих грибков и тяжело заболеть. У них может начаться мучительный кашель, тошнота, рвота, кровохаркание, сильные головные боли, повышение температуры тела .
Некоторые плесневые грибы выделяют опасные ядовитые вещества; вызываемые ими заболевания – микотоксикозы разрушают живые ткани организма человека и животных. В настоящее время исследователи насчитывают от 200 до 400 видов микотоксинов, причём лишь у немногих из них изучена степень токсичности. Даже самые малые их количества обладают нежелательным эффектом и способны со временем накапливаться в организме .
Причиной отравления людей и животных может быть также заражение сельскохозяйственных продуктов плесневыми грибами. Согласно данным Международной организации продовольствия (ФАО), в настоящее время в мире до 25% урожая зерновых культур ежегодно загрязняются микотоксинами.
Какие же грибы потенциально опасны для человека и сколько их? В настоящий момент общее число таких плесеней и дрожжей, по оценкам учёных, 300-400 видов.
1.2.2. Использование плесени в промышленности и сельском хозяйстве. Сформировавшееся в быту мнение, что плесень - это всегда плохо, к сожалению, обусловлено непониманием роли грибов в мире природы и в нашей жизни. Если рассуждать о плесенях с точки зрения человека, то они имеют массу полезных для него свойств. Столетия тому назад люди придумали использовать плесени для приготовления разных пищевых продуктов. Считается, что изначально ее получали с поверхности виноградин и слив (часто можно заметить белый налет на темных сливах - в его состав входит именно этот грибок). Этот микроорганизм обрабатывает сахар, превращая его в алкоголь и углекислый газ, превращая сусло в пиво. В Европе истинные плесени, имеющие развитый мицелий, используют при изготовлении сыров - французских рокфора, камамбера, бри, голубого датского, итальянской горгонцолы, английского стилтона. Применяют некоторые виды плесневых грибков и в виноделии. В русской народной медицине с лечебной целью применяли сухой толченый хлеб, поросший зеленой плесенью .
Многие плесени используют в пищевой и других отраслях промышленности для получения ряда ферментов, органических кислот, витаминов.
Опасные для насекомых плесневые грибы нужны для борьбы со многими насекомыми-вредителями, например колорадским жуком, картофельной коровкой, кукурузным мотыльком, свекловичным долгоносиком, щитовками, нематодами, клещами.
Основное свойство грибов - разлагать разнообразные органические субстраты - используют при очистке сточных вод.
Даже в авиастроении нашлось место плесневым грибам - при их участии изготавливают смеси, защищающие крылья самолётов от обледенения при взлёте и посадке.
Многие виды плесени применяют в целлюлозно-бумажной промышленности для переработки сырья и получения определённых сортов бумаги и картона из древесных и бумажных отходов.
1.2.3. Доктор «Плесень». Лечебные свойства плесени были открыты случайно в 1928 году. Ассистент английского биолога Александра Флеминга забыл закрыть окно на ночь, и утром оказалось, что некие споры покрыли образцы стафиллококов в открытом контейнере. Оказалось, что бактерии, которые окружила сине-зелёная плесень (см. Приложение, рис. 3) погибают и не способны размножаться. В 1929 году А. Флеминг выделил из зеленой плесени антибактериальное вещество . С тех пор плесень стали применять для получения различных лекарственных препаратов, например лекарств от мигрени, для лечения болезни Паркинсона и предотвращения образования тромбов.
Человеку впору поклониться плесени за то, что именно из неё в середине ХХ века был получен первый антибиотик - пенициллин, использование которого в медицине спасло жизнь миллионам людей. Ни одна операция в мире не обходится без пенициллиновой терапии. Пенициллин получил широкое применение для лечения инфекционных болезней.
Наряду с антибиотиками другими важнейшими веществами, получаемыми из плесеней, стали статины. Их считают главной группой лекарственных препаратов, используемых для снижения содержания холестерина.
Данный перечень полезных для человека веществ, создаваемых плесенями, конечно, не полный. На самом деле, сегодня из плесеней и при их помощи получают сотни разнообразных продуктов, без которых существование современного человечества невозможно!
1.3 Болезни хлеба
Заплесневение хлеба возникает при длительном хранении хлеба. Оно происходит в результате попадания спор плесени из окружающей среды на выпеченный хлеб. Оптимальные условия для развития плесени - температура 25-35° С и относительная влажность воздуха 70-80%. Плесневые грибы сначала поражают корку хлеба, а затем и мякиш. Ферменты плесени разлагают мякиш хлеба, портят его вкус и запах. Некоторые виды плесени образуют ядовитые вещества. Заплесневевший хлеб не пригоден к пище .
Заплесневение особенно опасно для хлеба, имеющего длительный срок хранения. Однако за последние годы произошли существенные изменения, и вырастить плесень на хлебе не всегда бывает так уж просто. Причина кроется в том, что сегодня во многие сорта хлеба добавляют специальные химические вещества, которые препятствуют развитию плесени. Их называют ингибиторами плесени. В частности имеются пищевые добавки, которые ингибируют (т.е. замедляют) рост плесени. Такие добавки иногда используются при изготовлении хлеба, который появляется на прилавках наших магазинов. Чтобы предупредить заплесневение, поверхность хлеба обрабатывают этиловым спиртом или сорбиновой кислотой (оба вещества являются консервантами), а затем упаковывают в мягкую тару. Можно добавлять химические консерванты (сорбиновую кислоту или уксуснокислый кальций) и в тесто. Хлеб с длительным сроком хранения, обработанный консервантами, сохраняется без порчи в течение нескольких месяцев.
1.4 Фитонциды в борьбе против плесени
Как же защитить продукты от плесени? Возможно, нам помогут растения, выделяющие фитонциды.
Растения могут выделять вещества, препятствующие росту микроорганизмов и низших грибов. Эти вещества называют фитонциды. Они обладают свойством убивать микроорганизмы, в т. ч. болезнетворные .
Летучие фитонциды – это эфирные масла, которые выделяют растения и защищают его от грибков и бактерий. Этими свойствами обладают лук, чеснок, горчица, гвоздика, душистый перец и другие. Известно, что лук и чеснок хорошо помогают в лечении против различных бактерий.
Летучие фитонциды впервые были обнаружены в природе в 1928–1930 гг. Было установлено, что пищевые продукты, приготовленные на восточных базарах, порой в совершенно антисанитарных условиях, почему-то не вызывают вспышек инфекционных заболеваний. Ученые предположили, что обилие восточных пряностей каким-то образом предохраняет продукты от порчи, а людей - от заражения кишечными инфекциями. Он исследовал вещества, содержащиеся в пряностях, и обнаружил, что значительный антисептический эффект вызывают именно летучие компоненты. Эти "летучие яды растений" он предложил назвать фитонцидами.
РАЗДЕЛ 2. МАТЕРИАЛ И МЕТОДИКА ИССЛЕДОВАНИЙ
В течение месяца наблюдений мы провели серию опытов.
2.1 Определение времени появления плесени на различных сортах хлеба
Для наблюдения мы взяли 3 сорта хлеба: белый, серый «Дарницкий» и зерновой. Куски хлеба поместили в пластиковые контейнеры и закрыли полиэтиленовой пленкой (см. рис.2.1.1). Наблюдения проводились ежедневно в течение 10 дней, данные заносились в таблицу.


№ 1 № 2 № 3
Рис.2.1.1 Образцы хлеба, взятого для исследования: № 1 – белый хлеб, № 2 – серый хлеб, № 3 – зерновой хлеб.
2.2 Определение влияние температуры на развитие плесени на хлебе
Для наблюдения мы взяли 3 куска хлеба одного сорта (зернового). Каждый кусок поместили в пластиковый контейнер, закрытый полиэтиленовой пленкой. 1-й контейнер оставили в комнате (температура +21+23 о С), 2-й поместили на верхнюю полку холодильника (температура +8+10 о С), 3-й – в морозильную камеру (температура – 16 о С). Наблюдения проводились в течение десяти дней, данные заносились в таблицу.
2.3 Определение влияния влажности на развитие плесени
Один кусок хлеба сбрызнули водой и поместили в пластиковый контейнер, закрытый полиэтиленовой пленкой. Второй кусок такого же хлеба завернули в бумажный пакет. Оба куска оставили при комнатной температуре. Результаты наблюдений представлены в таблице.
2.4 Определение влияния различных веществ на развитие плесени
Исследования проводились на чистой культуре плесени. Для этого кусочки плесневых спор размером приблизительно 3-5 мм с хлеба
специальной бактериологической петлей, прокаленной над пламенем
спиртовки, переносились в чашки Петри на питательную среду Сабуро (сахароза 40г/л, пептон 10г/л, агар-агар 20 г/л) (рис.2.4.1). Стерильные чашки Петри с питательной средой нам предоставили на кафедре ботаники и физиологии растений и биотехнологии Таврического национального университета им. В.И. Вернадского.

Рис.2.4.1 Перенос спор плесени с хлеба на питательную среду в чашки
Петри
Чашки Петри с культурой плесени пронумеровали и в каждую поочередно поставили пластмассовые крышечки: № 2 – с луком, № 3- с порошком горчицы, № 4 – с гранулами селикогеля (взяли из коробки для хранения обуви), № 5 - с чесноком, № 6 – с морской солью, № 7 – с настойкой йода. Одна чашка осталась контрольной (№ 1). В ней находилась только питательная среда с плесенью (см. Приложение, рис.4). Сравнение размеров плесени проводили на 3-й и 10-й дни наблюдения.
2.5 Определение влияния электромагнитного излучения СВЧ – печи на развитие плесени
Известно, что электромагнитное излучение приводит к нарушениям
жизненных процессов . Из литературных источников мы узнали, что ученые изобрели так называемую электромагнитную «пушку», которая позволяет сохранять хлеб без плесени до двух месяцев . Мы решили выяснить, влияет ли электромагнитное излучение в СВЧ-печи на развитие плесневых грибов.
Один кусок зернового хлеба поместили в микроволновую печь на 30 секунд. Более длительное нахождение в микроволновой печи приводит к высушиванию хлеба, что нецелесообразно, т. к. при этом резко уменьшается влажность хлеба, что само по себе может влиять на развитие плесени. Контрольный кусок хлеба не подвергался воздействию электромагнитных лучей.Исследуемый и контрольный образцы оставили для наблюдения при комнатной температуре. Для большей достоверности результатов такой же опыт мы провели с черным («Бородинским») хлебом. 2.6 Определение вида плесневых грибов на хлебе Образовавшуюся на хлебе плесень мы рассматривали под микроскопом (см. рис.2.6.1) и сравнивали с фотографиями плесневых грибов. Окончательно определение вида плесени проводилось на консультации со специалистами кафедры ботаники и физиологии растений и биотехнологии Таврического национального университета им. В.И. Вернадского.

Рис.2.6.1 Рассматривание под микроскопом образовавшейся на хлебе плесени
РАЗДЕЛ 3. РЕЗУЛЬТАТЫ ИССЛЕДОВАНИЯ
3.1 Время появления плесени на различных сортах хлеба.
Таблица 3.1.1
Образование плесени на различных сортах хлеба по дням наблюдения
Образцы хлеба
Дни наблюдения
Белый
Серый
Зерновой
1-3-й дни
без изменений
без изменений
без изменений
4-й день
появилось одно небольшое пятно зеленой плесени
без изменений
появилась 3 пятна зеленой плесени
5-й день
пятна увеличились и появились в толще хлеба
без изменений
весь кусок в зеленых пятнах плесени
6-й день
с нижней стороны появилась черная пушистая плесень
внутри коробки капли влаги, но плесени нет
плесень заняла большую часть хлеба, появилась черная пушистая плесень
7-й день
плесени стало больше, но меньше, чем на зерновом хлебе
без изменений
очень много плесени со всех сторон
8-10 й день
то же самое
снизу появились пятна плесени
весь кусок покрыт разноцветной плесенью со всех сторон
Раньше всего плесень появилась на зерновом хлебе, и к концу наблюдения этот хлеб больше всех был покрыт ею. На сером хлебе плесень появилась снизу только на 8-й день наблюдения, хотя в самом начале этот хлеб казался более влажным, чем остальные образцы. Можно предположить, что серый хлеб содержит большее количество консервантов – ингибиторов плесени. Таким образом, мы можем сделать вывод, что время образования плесени на различных сортах хлеба не одинаково.
3.2 Влияние температуры на развитие плесени на хлебе
Таблица 3.2.1
Появление плесени на хлебе в зависимости от температурных условий
Температура хранения
Дни наблюдения
Комнатная
21+ 25 о С
Полка в холодильнике +6+10 о С
Морозильник
16 о С
1-3-й дни
без изменений
без изменений
хлеб замерз и затвердел
4-й день
небольшая зеленоватая плесень
без изменений
без изменений
5-10-й дни
весь покрыт плесенью
затвердел
без изменений
По результатам, представленным в таблице можно сделать заключение, что наиболее комфортной для роста плесени является теплая среда(+21+25 о С). При очень низких температурах плесень на хлебе не развивается (см. Приложение, рис. 5).
3.3 Влияние влажности развитие плесени на хлебе
На куске хлеба, сбрызнутого водой и помещенного в пластиковый контейнер, закрытый пленкой, плесень появилась на 3-й день наблюдения. На 6-й день весь хлеб был покрыт зеленоватой плесенью с отдельными пятнами черной плесени. Кусок хлеба в бумажном пакете к 6-му дню наблюдения высох, плесень на нем не образовалось (см. Приложение, рис.6). Следовательно, влажная среда является необходимым условием для развития плесневых грибов.
3.4 Влияние различных веществ на рост плесневых грибов
Таблица 3.4.1
Развитие плесени под воздействием различных веществ
Дни наблюдения
Образцы
3-й день
10-й день
Контроль
Центральное пятно увеличилось в 2 раза, отдельные маленькие пятнышки по всей чашке Петри
Плесень разрослась почти по всей чашке Петри
Плесень + лук
Центральное пятно плесени увеличилось в 4 раза
Плесень + горчица
Пятно плесени почти не увеличилось
Центральное пятно увеличилось в 4 раза, несколько пятен по чашке
Плесень + селикогель
Пятно увеличилось в 3 раза, вокруг отдельные пятна плесени
Вся чашка Петри в плесени
Плесень + чеснок
Центральное пятно плесени увеличилось в раза, вокруг отдельные пятнышки
Чашка Петри вся заполнена плесенью
Плесень + морская соль
Мелкие пятнышки плесени по всей чашке, центральное пятно плесени почти не увеличилось
Центральное пятно увеличилось всего в два раза, стало больше маленьких пятнышек
Плесень + йод
Центральное пятно плесени увеличилось в 2 раза, вокруг пятен нет
Центральное пятно немного увеличилось, вокруг появилось несколько пятнышек
Предположение, что фитонциды лука и чеснока тормозят развитие плесени, не подтвердилось. В образцах с луком и чесноком количество плесени к концу наблюдения было даже больше, чем в контрольном образце. Возможно, это связано с тем, что сырые кусочки лука и чеснока увеличивают влажность, а влажная среда благоприятна для роста плесени. Сильнее всего задерживает рост плесневых грибов горчица.
Гранулы селикогеля быстро впитывали влагу и в дальнейшем росту плесени не препятствовали. Лучше всего задерживала рост плесени настойка йода и морская соль (см. Приложение, рис.7, рис. 8).
Из проведенного опыта можно сделать следующий вывод, что для лучшего хранения хлеба в хлебнице, чтобы хлеб в ней не портился, следует помещать порошок горчицы, морскую соль или настойку йода.
3.5 Влияние электромагнитного излучения СВЧ- печи на развитие хлебной плесени
На контрольных образцах зернового и бородинского хлеба плесень появилась на 5-й день наблюдения, на опытных образцах плесени не было (см. Приложение, рис.9). На зерновом хлебе, который помещали в СВЧ- печь на 30 сек, развитие плесневых грибов не наблюдалось и на 10-й день исследования. На опытном куске хлеба «Бородинский» маленькие пятнышки плесени начали появляться только на 10- день наблюдения. Следовательно, электромагнитное излучение в СВЧ-печи значительно задерживает развитие плесени на хлебе.
3.6 Определение вида плесневых грибов на хлебе
За все время наблюдений мы обнаружили, что на кусках хлеба образовывалась различная плесень (см. Приложение, рис. 10). Рассматривая кусочки плесени под микроскопом и сравнивая с фотографиями различных плесневых грибов мы определили: черная плесень это головчатая хлебная плесень Mucor Mucedo (серебристо-белые нити, увенчанные на верхушке маленькими черными шариками меньше булавочной головки); а зеленоватая плесень это сизая хлебная плесень Penicillium glaucum – зеленый кистевик (зеленый оттенок зависит от цвета спор) (см. Приложение, рис.11). Наши предположения подтвердили специалисты кафедры ботаники и физиологии растений и биотехнологии ТНУ им. В.И. Вернадского.
Что необходимо знать о правильном хранении хлеба?
1. Не следует хранить хлеб в полиэтиленовых пакетах. За счет испарения воды из хлеба в них создается повышенная влажность, способствующая развитию плесени;
2. Разные сорта хлеба лучше хранить отдельно.
3. Не стоит убирать в пакет свежий горячий хлеб, подождите, пока он остынет. Теплый хлеб «задыхается»: сначала он лишается хрустящей корочки, а позже становится пищей для плесени.
4. Хлебницу лучше держать в открытом, хорошо освещенном месте возле окна. В темных углах гораздо труднее бороться с плесенью.
5. Положите в хлебницу горсточку соли (как известно, соль – это известный консервант, который предотвращает развитие микрооорганизмов), завернутый в марлю порошок горчицы или ватку с каплями йода.
6. Поместите буханку хлеба перед хранением в СВЧ – печь на 30 сек.
А лучше всего, если нет особой необходимости, не покупайте хлеб впрок. Берите столько хлеба, сколько можете съесть в течение 1-3 дней.
ВЫВОДЫ
Время образования плесени на различных сортах хлеба не одинаковое. Оно может зависеть от содержания влаги в хлебе, от добавления в него различных консервантов - ингибиторов плесени или же от первоначального заражения зерна и муки спорами плесневых грибов.
Влажная и теплая среда – основное условие для развития плесени.
Больше всего замедляют рост плесневых грибов фитонциды горчицы, морская соль и настойка йода.
Нахождение хлеба в СВЧ-печи в течение 30сек существенно задерживает образование на нем плесени.
На хлебе в основном развиваются два вида плесневых грибов: головчатая хлебная плесень и сизая хлебная плесень.
Данные в работе рекомендации по правильному хранению хлеба помогут защитить себя и свою семью от неприятной встречи с плесенью. Плесень можно сравнить с огнем. Она может и навредить, и принести большую пользу. Многое зависит от того, как мы ее используем и умеем ли контролировать.
СПИСОК ЛИТЕРАТУРНЫХ ИСТОЧНИКОВ
1. Блинкин С.А. Фитонциды вокруг нас. / С.А. Блинкин, Т.В. Рудницкая // М., 1981.- 185 с.
2. Буянов. Н.Ю. Я познаю мир.// Медицина. Энциклопедия для детей. - Москва: ООО « Издательство АСТ ЛТД ». - 1997 г. 3. Энциклопедия для детей. Том 14. Биология // Глав. редактор В. Володин. – М.: Аванта+, 2004. – 640 с.
4. www /hlebopechka .net /h 80/php
5.
6. www/teflex.ru/all-about-mold
7. www . popmech . ru / articles /255- o - polze - plesen /
8. log -in .ru /articles /plesen -khoroshaya -i -plokhaya /
9. http:/www/pole.com.ru
10.http ://www .watchtowes .org /u /index /htmi
11.www.vesti.ru /doc .htm /974227/
ПРИЛОЖЕНИЕ


 Рис. 1 Строение плесневого гриба.
Рис. 1 Строение плесневого гриба.
 а) б) в)
а) б) в)
Рис. 2 Плесень вокруг нас: а) плесень на хлебе; б) плесень на сыре; в) плесень в сырой комнате.

Рис. 3 Увеличенное изображение плесневого гриба Penicillium notatum, их которого был получен антибиотик пенициллин.





Рис.4 Споры плесени, пересаженные в чашки Петри с различными веществами: № 1 – контроль, № 2 – с луком, № 3 – с горчицей, № 4 – с гранулами селикогеля, № 5 – с чесноком, № 6 – с солью, № 7 – с йодом.

№ 1 № 2 № 3
Рис. 5 Вид зернового хлеба на 10-й день наблюдения: № 1 – хлеб из морозилки, № 2 – хлеб с верхней полки холодильника, № 3 – хлеб из комнаты.

№ 1 № 2
Рис. 6 Вид зернового хлеба на 6-й день наблюдения: № 1 – хлеб, сбрызнутый водой, в пластиковом контейнере; № 2 – хлеб в бумажном пакете.




Рис. 7 Вид плесени на 3-й день наблюдения: № 1 – контроль, № 2 – с луком, № 3 – с горчицей, № 4 – с селикогелем, № 5 – с чесноком, № 6 – с морской солью, № 7 – с йодом.

Рис. 8 Вид плесени на 10-й день наблюдения: № 1 – контроль, № 2 – с луком, № 3 – с горчицей, № 4- с чесноком, № 5- с селикогелем, № 6 – с морской солью, № 7 - с йодом.

А) б)
Рис. 9 Влияние электромагнитного излучения на развитие плесени: а) хлеб, который помещали на 30 сек в СВЧ- печь, на 5-й день наблюдения; б) контрольный образец хлеба на 5-й день наблюдения.

А) б)
Рис. 10 Различные виды плесени на хлебе: а) два вида плесени на зерновом хлебе; б) черная плесень на хлебе «Бородинский».


А) б)
Рис. 11 Виды плесневых грибов на хлебе: а) Penicillium glaucum –сизая хлебная плесень, зеленый кистевик (увеличение 1200р); б) Mucor Mucedo – головчатая хлебная плесень.



